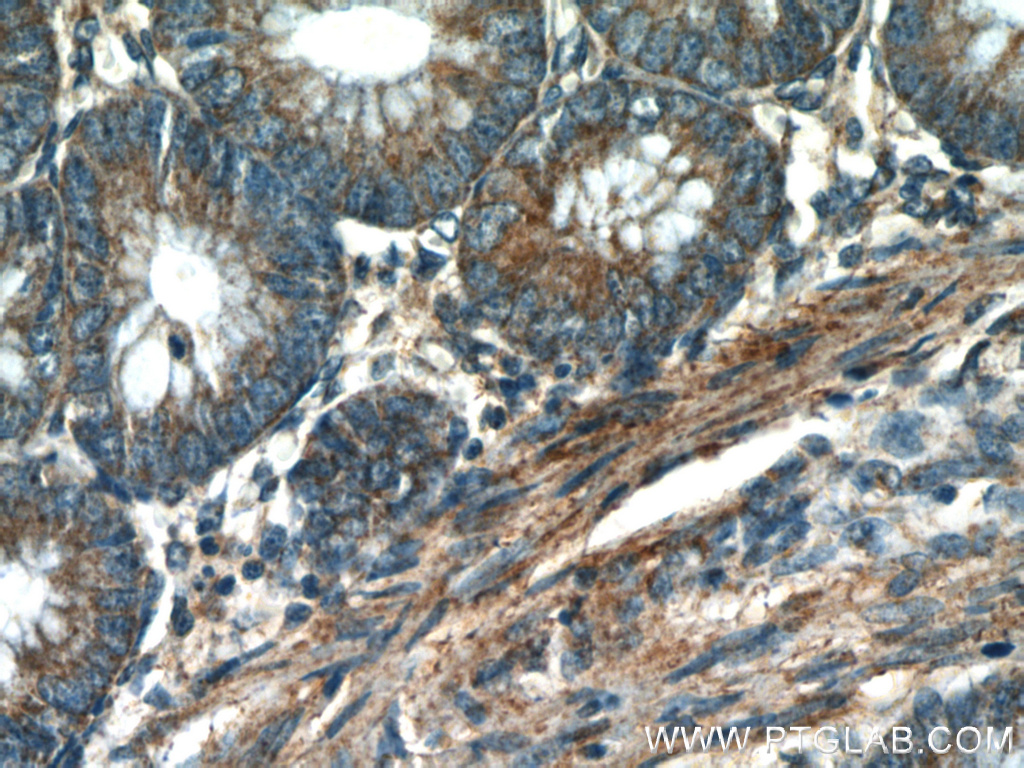

验证数据展示
经过测试的应用
| Positive WB detected in | HEK-293 cells, 4T1 cells, HepG2 cells, mouse kidney tissue, MCF-7 cells, MDA-MB-453s cells, Jurkat cells, C6 cells, rat kidney tissue |
| Positive IHC detected in | human colon tissue, mouse heart tissue Note: suggested antigen retrieval with TE buffer pH 9.0; (*) Alternatively, antigen retrieval may be performed with citrate buffer pH 6.0 |
| Positive IF-P detected in | mouse liver tissue, human liver cancer tissue |
| Positive IF-Fro detected in | mouse liver tissue |
| Positive FC (Intra) detected in | HepG2 cells |
推荐稀释比
| 应用 | 推荐稀释比 |
|---|---|
| Western Blot (WB) | WB : 1:500-1:3000 |
| Immunohistochemistry (IHC) | IHC : 1:50-1:500 |
| Immunofluorescence (IF)-P | IF-P : 1:200-1:800 |
| Immunofluorescence (IF)-FRO | IF-FRO : 1:50-1:500 |
| Flow Cytometry (FC) (INTRA) | FC (INTRA) : 0.80 ug per 10^6 cells in a 100 µl suspension |
| It is recommended that this reagent should be titrated in each testing system to obtain optimal results. | |
| Sample-dependent, Check data in validation data gallery. | |
产品信息
10866-1-AP targets VDAC1/2 in WB, IHC, IF-P, IF-Fro, FC (Intra), CoIP, ELISA applications and shows reactivity with human, mouse, rat samples.
| 经测试应用 | WB, IHC, IF-P, IF-Fro, FC (Intra), ELISA Application Description |
| 文献引用应用 | WB, IHC, IF, CoIP |
| 经测试反应性 | human, mouse, rat |
| 文献引用反应性 | human, mouse, rat, pig, rabbit, monkey, zebrafish, pieris rapae |
| 免疫原 |
CatNo: Ag1144 Product name: Recombinant human Porin protein Source: e coli.-derived, PGEX-4T Tag: GST Domain: 1-283 aa of BC008482 Sequence: MAVPPTYADLGKSARDVFTKGYGFGLIKLDLKTKSENGLEFTSSGSANTETTKVTGSLETKYRWTEYGLTFTEKWNTDNTLGTEITVEDQLARGLKLTFDSSFSPNTGKKNAKIKTGYKREHINLGCDMDFDIAGPSIRGALVLGYEGWLAGYQMNFETAKSRVTQSNFAVGYKTDEFQLHTNVNDGTEFGGSIYQKVNKKLETAVNLAWTAGNSNTRFGIAAKYQIDPDACFSAKVNNSSLIGLGYTQTLKPGIKLTLSALLDGKNVNAGGHKLGLGLEFQA 种属同源性预测 |
| 宿主/亚型 | Rabbit / IgG |
| 抗体类别 | Polyclonal |
| 产品类型 | Antibody |
| 全称 | voltage-dependent anion channel 1 |
| 别名 | Porin, VDAC1, VDAC1/Porin, hVDAC1, Plasmalemmal porin |
| 计算分子量 | 31 kDa |
| 观测分子量 | 31 kDa |
| GenBank蛋白编号 | BC008482 |
| 基因名称 | Porin |
| Gene ID (NCBI) | 7416 |
| RRID | AB_2257153 |
| 偶联类型 | Unconjugated |
| 形式 | Liquid |
| 纯化方式 | Antigen affinity purification |
| UNIPROT ID | P21796 |
| 储存缓冲液 | PBS with 0.02% sodium azide and 50% glycerol, pH 7.3. |
| 储存条件 | Store at -20°C. Stable for one year after shipment. Aliquoting is unnecessary for -20oC storage. |
背景介绍
VDAC1, also named as VDAC, porin 31HM, porin 31HL and plasmalemmal porin, belongs to the eukaryotic mitochondrial porin family. It adopts an open conformation at low or zero membrane potential and a closed conformation at potentials above 30-40 mV, to form a channel through the mitochondrial outer membrane and also the plasma membrane. Unlike other membrane transport proteins, porins are large enough to allow passive diffusion. Studies have shown that VDAC1 is subject to both phosphorylation and acetylation (PMID: 23233904). The apparent molecular weight of VDAC1 is 30-37 kDa (PMID: 14573604; 23754752; 25681439). Hypoxic conditions were found to trigger cleavage of the VDAC1 C-terminal to yield a 26-kDa truncated but active form (PMID: 22389449; 23233904). This polyclonal antibody raised against full-length human VDAC1 protein can cross react with VDAC2.
实验方案
| Product Specific Protocols | |
|---|---|
| FC protocol for VDAC1/2 antibody 10866-1-AP | Download protocol |
| IF protocol for VDAC1/2 antibody 10866-1-AP | Download protocol |
| IHC protocol for VDAC1/2 antibody 10866-1-AP | Download protocol |
| WB protocol for VDAC1/2 antibody 10866-1-AP | Download protocol |
| Standard Protocols | |
|---|---|
| Click here to view our Standard Protocols |
发表文章
| Species | Application | Title |
|---|---|---|
Signal Transduct Target Ther Targeting CRL4 suppresses chemoresistant ovarian cancer growth by inducing mitophagy | ||
Nat Cell Biol AIDA directly connects sympathetic innervation to adaptive thermogenesis by UCP1. | ||
Cell Rep Med Urolithin A improves muscle strength, exercise performance, and biomarkers of mitochondrial health in a randomized trial in middle-aged adults. | ||
Cell Res DNA damage triggers tubular endoplasmic reticulum extension to promote apoptosis by facilitating ER-mitochondria signaling. | ||
Acta Pharm Sin B Histone deacetylase inhibitors inhibit cervical cancer growth through Parkin acetylation-mediated mitophagy. | ||